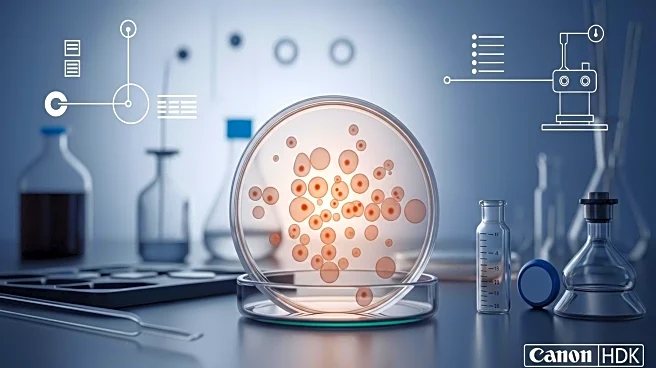

What's Happening?
Scientists have successfully created human eggs using genes from adult skin cells, a breakthrough that could potentially assist infertile women and gay couples in having genetically related children. This research, led by Shoukhrat Mitalipov at Oregon Health & Science University, involves a technique known as in vitro gametogenesis. The process uses skin cells to create eggs, which are then fertilized to develop into embryos. Although the embryos reached the blastocyst stage, they still contained genetic abnormalities preventing further development. The research, published in Nature Communications, represents a significant step forward in reproductive technology.
Why It's Important?
The development of human eggs from skin cells could revolutionize reproductive medicine, offering new possibilities for individuals unable to conceive naturally. This technology could enable gay couples to have children genetically related to both partners, expanding family-building options. However, it also raises ethical concerns, such as the potential for 'designer babies' and unauthorized use of genetic material. The implications of this technology are vast, affecting societal norms, legal frameworks, and ethical standards in reproductive health.
What's Next?
Further research is needed to address the genetic abnormalities found in the embryos and to ensure the safety and efficacy of the technology. Scientists are exploring various approaches to perfect the process, with hopes of overcoming current limitations. Ethical debates are likely to intensify as the technology progresses, necessitating careful consideration and regulation to prevent misuse and protect individual rights.
Beyond the Headlines
The ability to create human eggs from skin cells could lead to profound changes in how society views reproduction and genetic inheritance. It challenges traditional concepts of parenthood and could influence cultural attitudes towards family and genetic identity. The technology also poses risks of exploitation and privacy violations, highlighting the need for robust ethical guidelines and oversight.